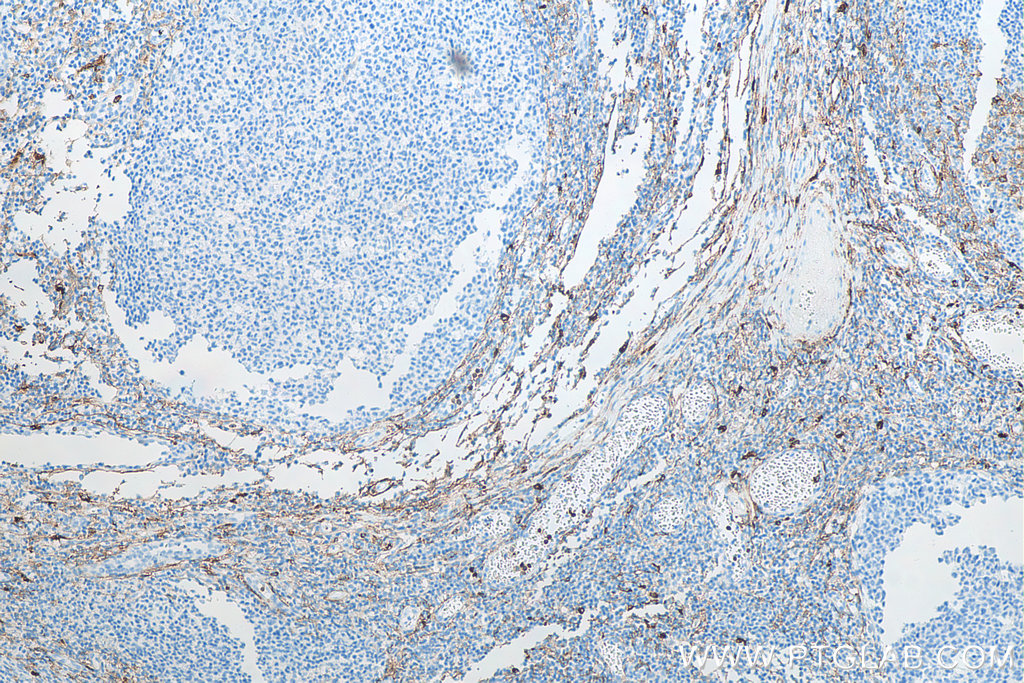

验证数据展示
经过测试的应用
| Positive WB detected in | U-937 cells |
| Positive IHC detected in | human kidney tissue, human tonsillitis tissue, mouse kidney tissue, rat kidney tissue Note: suggested antigen retrieval with TE buffer pH 9.0; (*) Alternatively, antigen retrieval may be performed with citrate buffer pH 6.0 |
| Positive IF-P detected in | mouse kidney tissue, human kidney tissue |
| Positive IF/ICC detected in | THP-1 cells |
推荐稀释比
| 应用 | 推荐稀释比 |
|---|---|
| Western Blot (WB) | WB : 1:3000-1:8000 |
| Immunohistochemistry (IHC) | IHC : 1:5000-1:20000 |
| Immunofluorescence (IF)-P | IF-P : 1:200-1:800 |
| Immunofluorescence (IF)/ICC | IF/ICC : 1:400-1:1600 |
| It is recommended that this reagent should be titrated in each testing system to obtain optimal results. | |
| Sample-dependent, Check data in validation data gallery. | |
产品信息
66211-1-Ig targets CD13 in WB, IHC, IF/ICC, IF-P, ELISA applications and shows reactivity with human, mouse, rat samples.
| 经测试应用 | WB, IHC, IF/ICC, IF-P, ELISA Application Description |
| 文献引用应用 | WB, IHC, IF |
| 经测试反应性 | human, mouse, rat |
| 文献引用反应性 | human, mouse, rat |
| 免疫原 |
CatNo: Ag5976 Product name: Recombinant human ANPEP protein Source: e coli.-derived, PGEX-4T Tag: GST Domain: 609-967 aa of BC058928 Sequence: NDLFSTSGNEWVLLNLNVTGYYRVNYDEENWRKIQTQLQRDHSAIPVINRAQIINDAFNLASAHKVPVTLALNNTLFLIEERQYMPWEAALSSLSYFKLMFDRSEVYGPMKNYLKKQVTPLFIHFRNNTNNWREIPENLMDQYSEVNAISTACSNGVPECEEMVSGLFKQWMENPNNNPIHPNLRSTVYCNAIAQGGEEEWDFAWEQFRNATLVNEADKLRAALACSKELWILNRYLSYTLNPDLIRKQDATSTIISITNNVIGQGLVWDFVQSNWKKLFNDYGGGSFSFSNLIQAVTRRFSTEYELQQLEQFKKDNEETGFGSGTRALEQALEKTKANIKWVKENKEVVLQWFTENSK 种属同源性预测 |
| 宿主/亚型 | Mouse / IgG2a |
| 抗体类别 | Monoclonal |
| 产品类型 | Antibody |
| 全称 | alanyl (membrane) aminopeptidase |
| 别名 | AP-M, ANPEP, Aminopeptidase N, Aminopeptidase M, Alanyl aminopeptidase |
| 计算分子量 | 110 kDa |
| 观测分子量 | 150 kDa |
| GenBank蛋白编号 | BC058928 |
| 基因名称 | CD13 |
| Gene ID (NCBI) | 290 |
| ENSEMBL Gene ID | ENSG00000166825 |
| RRID | AB_2881602 |
| 偶联类型 | Unconjugated |
| 形式 | Liquid |
| 纯化方式 | Protein A purification |
| UNIPROT ID | P15144 |
| 储存缓冲液 | PBS with 0.02% sodium azide and 50% glycerol, pH 7.3. |
| 储存条件 | Store at -20°C. Stable for one year after shipment. Aliquoting is unnecessary for -20oC storage. |
背景介绍
CD13, also named as APN, ANPEP(aminopeptidase N) or PEPN, is belongs to the peptidase M-1 family. CD13 is a heavily glycosylated, ~150-240 kDa, type-II membrane, expressed by most cells of myeloid origin including monocytes, macrophages, granulocytes, and their hematopoietic precursors. It is also abundantly expressed in the brush border of epithelial cells from renal proximal tubules and small intestine, in prostatic epithelial cells, in bile duct canaliculi, in mast cells, and, in some cases, in fibroblasts and smooth muscle cells. CD13 is a multifunctional protein and plays varying roles in cell migration, cell proliferation, cell differentiation and so on. CD13 participates in angiogenesis generating and modulating angiogenic signals, and can be a marker of angiogenic vessels. CD13 is also a pan-myeloid marker, present on mature granulocytes and monocytes. (PMID: 8805662, 10098327, 18603472, 18097955, 17897790, 17888402, 21339174)
实验方案
| Product Specific Protocols | |
|---|---|
| IF protocol for CD13 antibody 66211-1-Ig | Download protocol |
| IHC protocol for CD13 antibody 66211-1-Ig | Download protocol |
| WB protocol for CD13 antibody 66211-1-Ig | Download protocol |
| Standard Protocols | |
|---|---|
| Click here to view our Standard Protocols |
发表文章
| Species | Application | Title |
|---|---|---|
Cell Stem Cell Human airway submucosal gland organoids to study respiratory inflammation and infection | ||
Mol Cell Proteomics Profiling the Surfaceome Identifies Therapeutic Targets for Cells with Hyperactive mTORC1 Signaling. | ||
Sci Rep Proteomic Profiling of Small Extracellular Vesicles Secreted by Human Pancreatic Cancer Cells Implicated in Cellular Transformation. | ||
Cancer Manag Res Liver-enriched activator protein 1 as an isoform of CCAAT/enhancer-binding protein beta suppresses stem cell features of hepatocellular carcinoma. | ||
Biol Pharm Bull Spautin-A41 Attenuates Cerulein-Induced Acute Pancreatitis through Inhibition of Dysregulated Autophagy. | ||
Transl Cancer Res Ubenimex suppresses glycolysis mediated by CD13/Hedgehog signaling to enhance the effect of cisplatin in liver cancer |